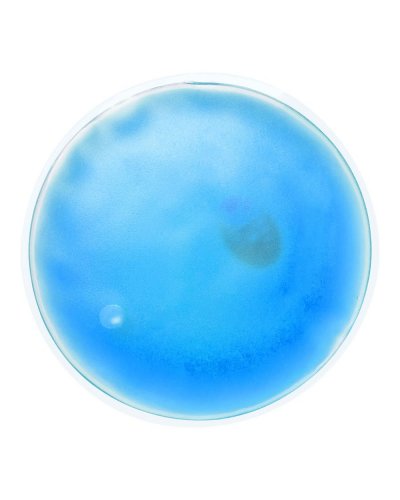
Scaldamani riutilizzabile Kinson Blu

Disponibilità immediata
| Materiale | Plastica |
| Misure | ø 10 ×1 cm |
| Peso | 64 gr |
| Materiale | Plastica |
| Misure | ø 10 ×1 cm |
| Peso | 64 gr |
Prezzo da:
€ 0,44
Iva esclusa
€ 0,44
Iva esclusa
Trasporto gratuito per ordini superiori a € 100
Disponibilità immediata
Ti servono quantità maggiori/minori?
CALCOLA PREVENTIVO

2375
recensioni
Quando riceverò questo prodotto?
Puoi ricevere questo prodotto in 15 giorni lavorativi.
Ovvero il: 07/07/2026
06/07/2026
+ € 11,00
03/07/2026
+ € 12,00